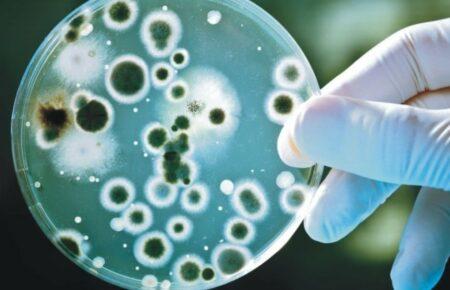
Лікарка розповіла, які інфекційні захворювання активізуються після затоплення територій

Здоров'я
Здоров'я


Що їсти, щоб не зіпсувати романтичний вечір

«З понеділка!»: на Громадському радіо стартує новий сезон подкасту про те, як почуватися комфортно у власному тілі

«Ми їдемо туди, де медицина недоступна» — СЕО благодійного фонду Fortitude Андрій Запітецький

Популярний сервіс Tabletki.ua перейшов у власність «Київстару»

Укласти декларацію з сімейним лікарем тепер можна онлайн

«Неможливо інтуїтивно підібрати здоровий раціон для улюбленців» — лікарка ветеринарної медицини Юлія Романишина

Алергія на холод: що це таке і хто в зоні ризику

Що їсти в мороз, щоб зберегти тепло: поради нутриціологині

В Україні зросла кількість випадків інфікування сказом: у чому причина і до чого тут війна

Центр крові ЗСУ потребує щоденно від 50 до 100 донорів, — волонтерка

Як уберегтися від переохолодження та обмороження взимку

Військові й далі мають проблеми з надходженням крові: які причини

В Україні стартувала програма скринінгу здоров’я для тих, кому 40 років і більше: як скористатися

Броньована капсула НРК врятувала пораненого військового під час евакуації на передовій (ВІДЕО)

У Львівському госпіталі лікарі відновили пораненому військовому 12,5 см кістки

Що означає бути інтерсекс-людиною

PROMOTEDЛікування безпліддя у чоловіків

Правда про серцево-судинні захворювання: як оцінити ризики у 25 років